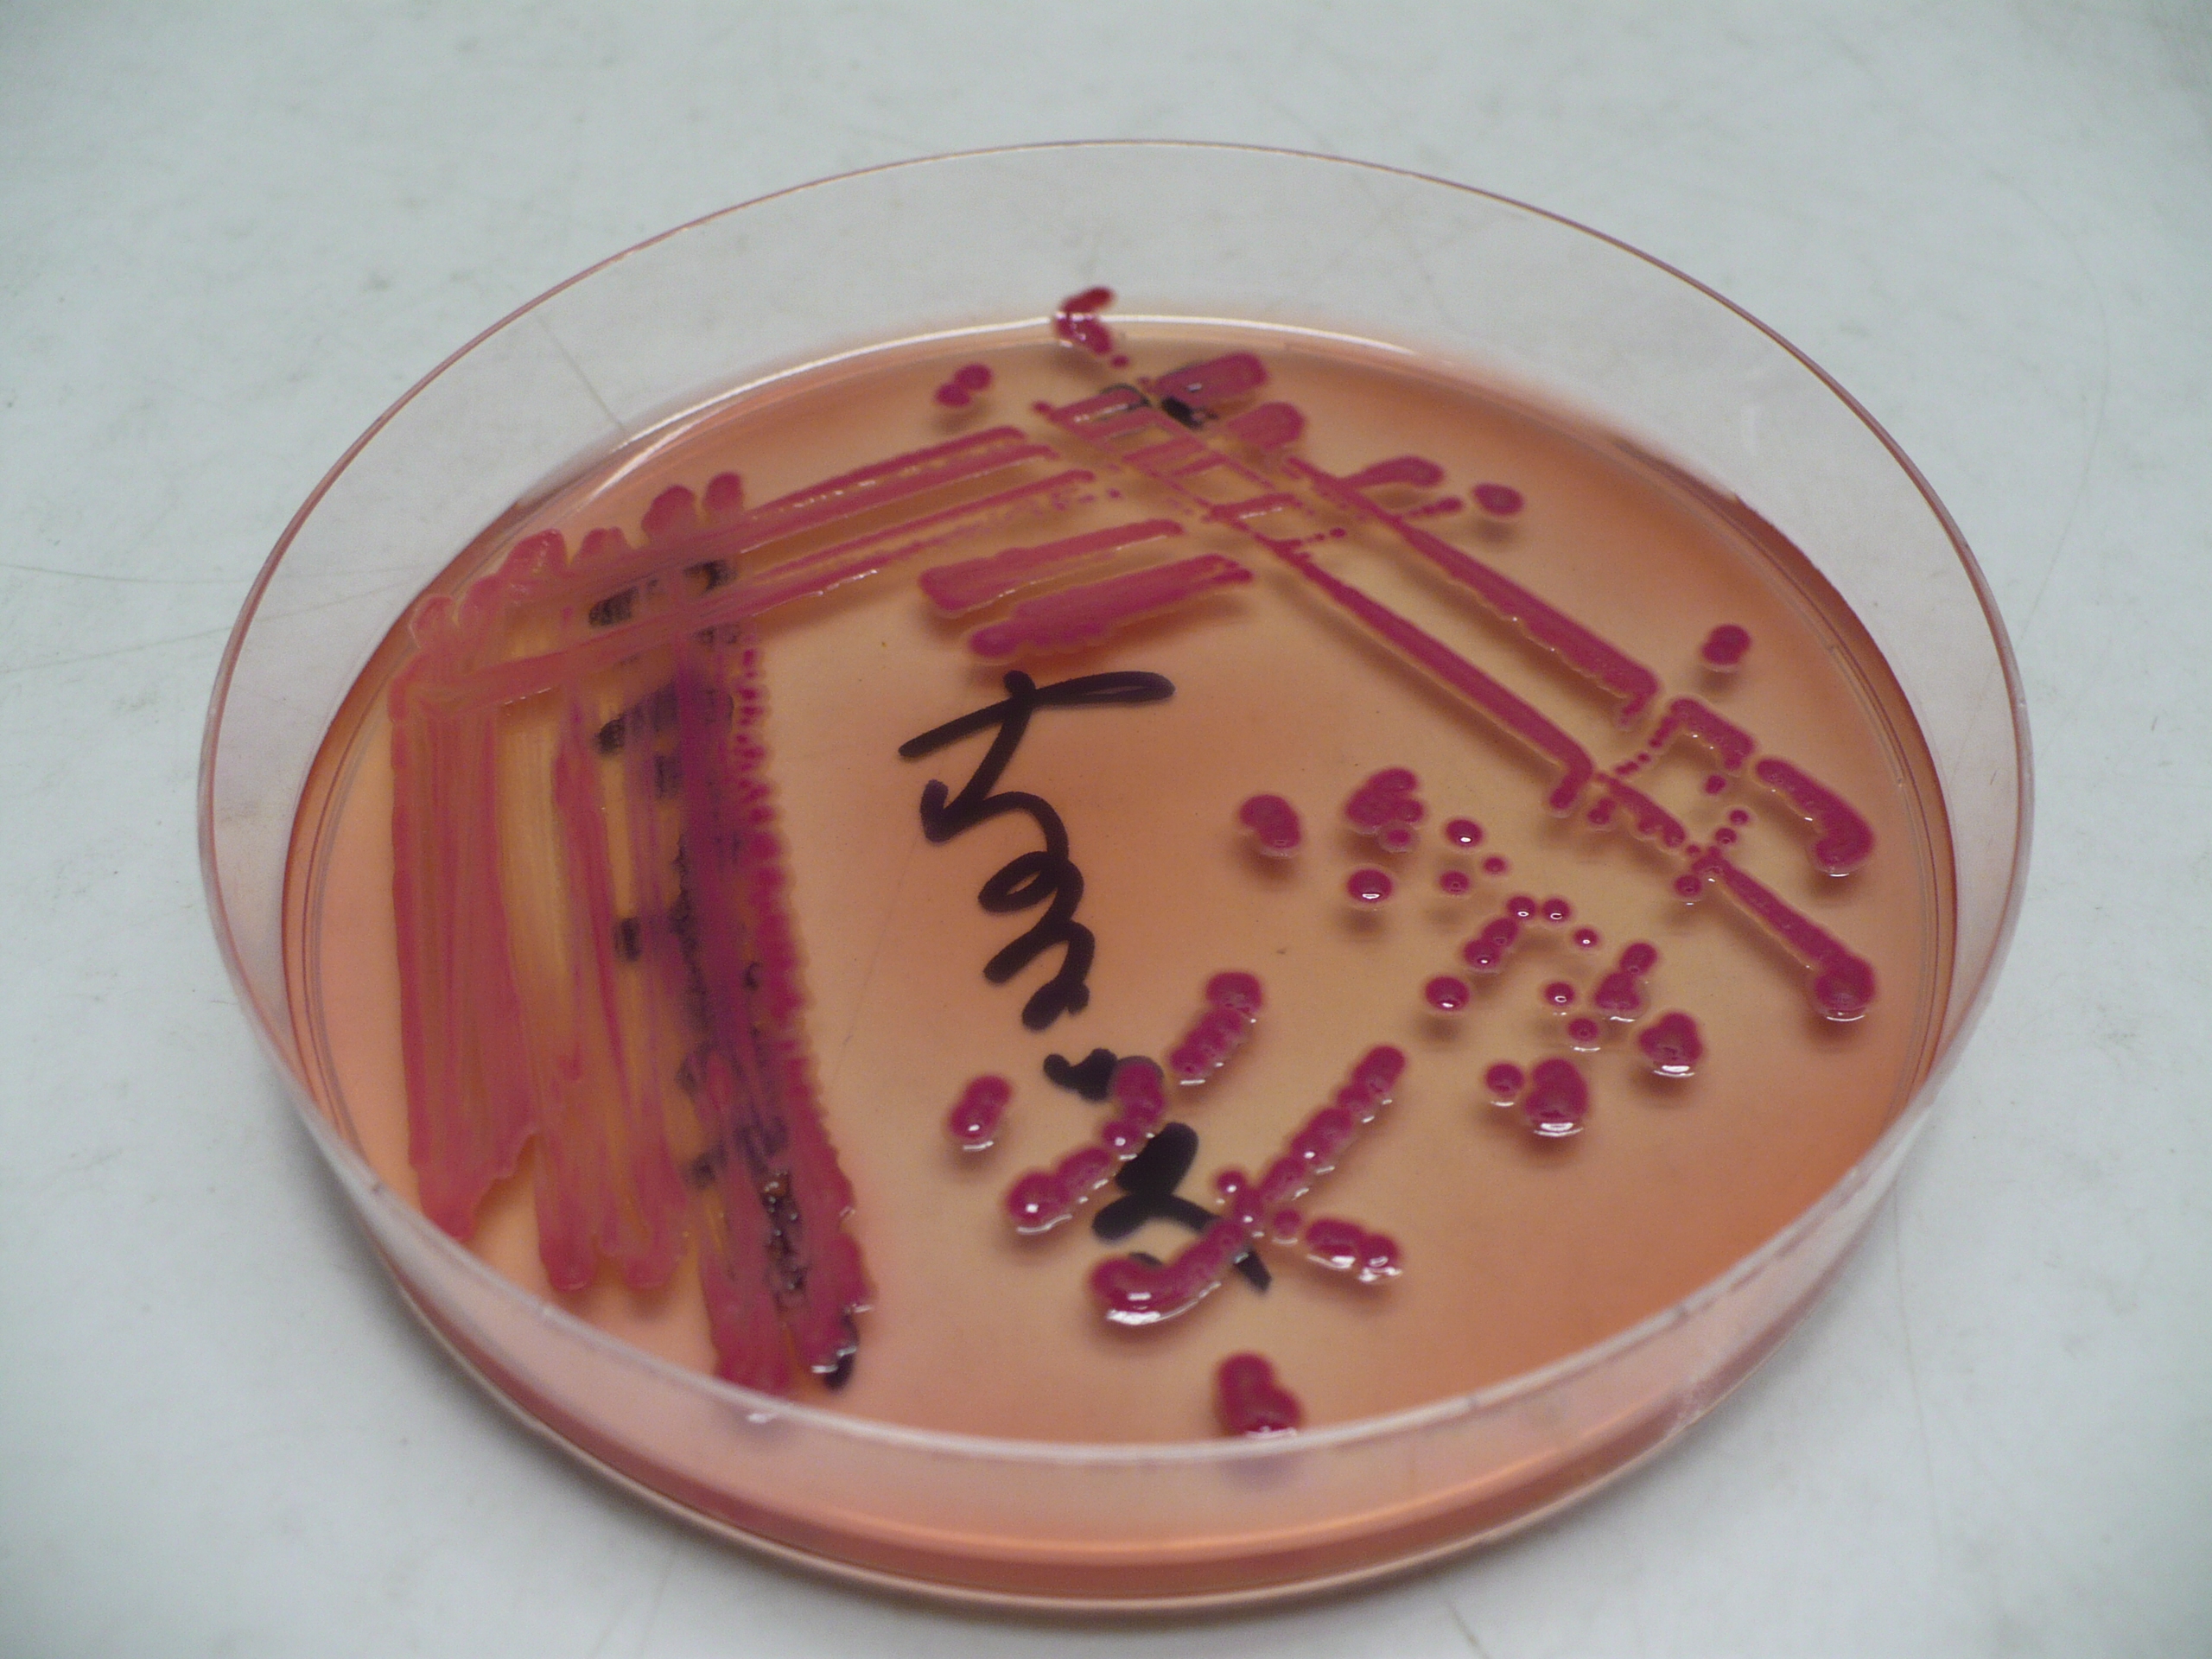

Фотографии бактерий цитробактер у животных и под микроскопом

:format(webp)/cdn.vox-cdn.com/uploads/chorus_asset/file/14458000/Screen_Shot_2013-09-17_at_11.57.57_AM.1419979910.png)
























































Раздел: Другие животные